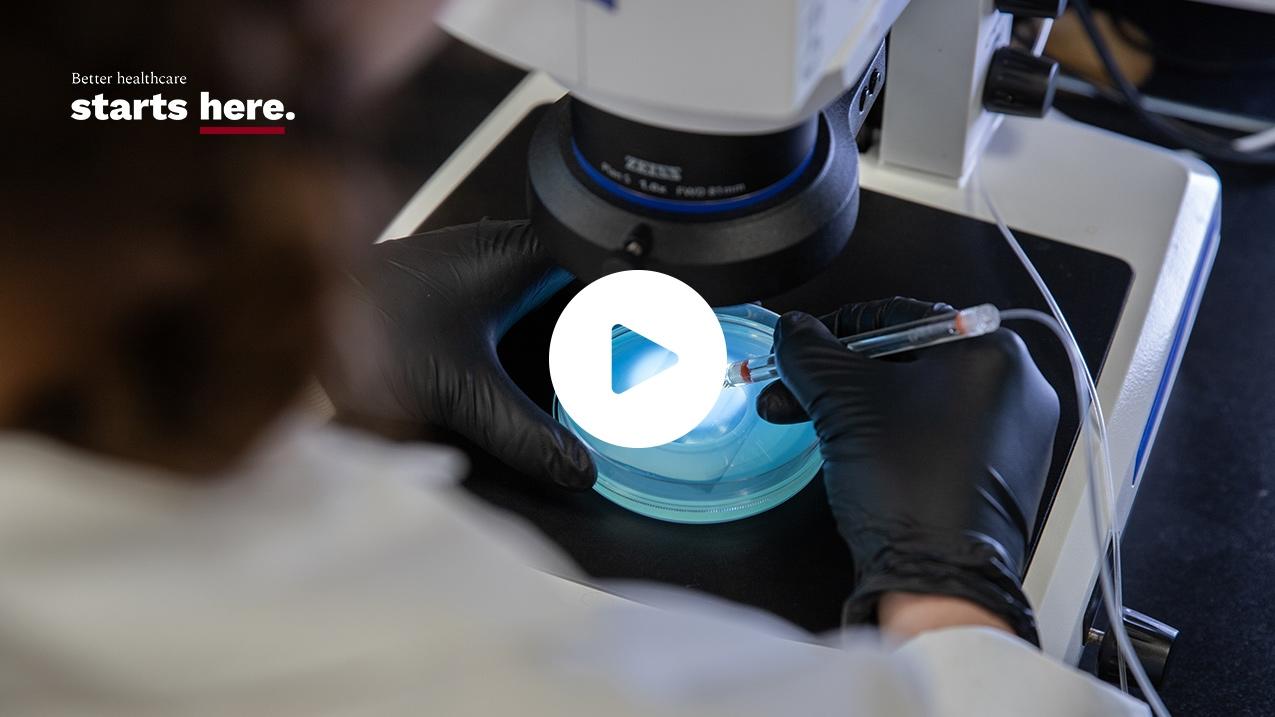
View over the shoulder of a person, looking at a sample looking at a sample under the microscope

“In my world of pediatric oncology, up to three-quarters of patients are involved in a clinical trial because that is considered the standard of care. The treatments we give today are based on yesterday’s research discoveries,” says Dr. Berman, who is also vice-president of research at CHEO, as well as CEO and scientific director of CHEO’s Research Institute.
From his office, he can look across the street to see the construction of uOttawa’s Advanced Medical Research Centre (AMRC), which is scheduled to open in 2026. “I see it as a virtuous cycle, where clinical care can be informed by discovery. And if we have people closer together on the same campus, those advancements can happen more rapidly and it is our local patients who are going to be the first to benefit from discoveries made at the AMRC,” he explains.

“[Our] local patients … are going to be the first to benefit from discoveries made at the AMRC.”
Dr. Jason Berman
— uOttawa pediatrics professor
Built on the site of uOttawa’s Faculty of Medicine and adjacent to local hospitals, the AMRC will be a seven-story building that will promote collaborative research between some of the world’s top scientists and clinicians caring for patients in our public health system. It is uOttawa’s largest-ever investment and responds to a longstanding shortage of lab space needed to enhance the medical care that every family relies on.
Thanks to its hotbed of talent and cutting-edge infrastructure, the AMRC will fuel innovation that can revolutionize how health care is delivered here in the nation’s capital and beyond, and allow our thriving research ecosystem to better compete on a global scale.
Dr. Berman says that having research in proximity to health care is critical. “I don’t think any of us want to be treated in a hospital that does things the way they did it ten years ago if there’s data that now suggests that there’s a better way to do it. I think people got a better appreciation of that during the pandemic.”
One full floor of the AMRC is set to become an innovation hub, where researchers will be able to interact with industry partners to incubate biotech startups and accelerate discoveries of next-generation medical treatments and technologies. Cutting-edge science conducted at the AMRC will change our understanding of the world at the molecular level, and strategic partnerships forged with industry and government will improve millions of lives by providing better standards of care.
Dr. Sharon Johnston says that this kind of collaboration is essential in order for Ottawa to realize its full potential as a biotech capital. “We just can’t rely on our hospitals and our government-funded research alone. When industry has early access to researchers, they bring resources and talent, and together they form startups. We need those partnerships to advance new therapies and ultimately, the best care,” she says.
A family physician, Dr. Johnston is also an associate professor at uOttawa and scientific director and associate vice-president of L’Institut du Savoir Montfort, a research centre located in the region’s only Francophone hospital. Among her areas of research is the care and recovery of people who have experienced a concussion.

“The AMRC will drive discoveries that will ultimately translate into better care for our patients.”
Dr. Sharon Johnston
— uOttawa professor; scientific director and associate vice-president of L’Institut du Savoir Monfort
“You need a community, a destination. The AMRC will be that resource. You want the researchers mixing with the doctors, nurses, respiratory technicians. People who can help make research more relevant by explaining the symptoms and signs they are observing and the treatment decisions they are making. The researchers might then give more priority to studying a certain type of protein based on what they observe in patients,” she explains.
Dr. Johnston sees a lot of potential in collaborating with others to increase sample sizes and to share resources. “It’s never acceptable to feel like you’ve reached the limit,” says Dr. Johnston. “The AMRC will drive discoveries that will ultimately translate into better care for our patients.”
For more information on the AMRC and how to support Canadian research, health-care innovation and patient well-being, please contact uOttawa’s Executive Director of Corporate Development Jonathan Bodden at jbodden@uOttawa.ca or 613-614-3571.